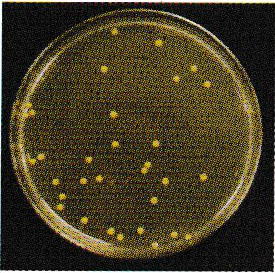

木酢入浴液 の特徴・使用方法・注意事項
MOKUSAKU BATHING SOLUTION
木酢液とは
人口では作る事ことの出来ない、樹木からのエキスをたっぷりと含んだ液体。それが木酢液です。
木材を炭焼きと同じように窯の中で蒸し焼きにすると、多量の煙が出てきます。この煙を集めて冷やし静かに置いておくと、上層(黄色っぽい軽質油分)、中間層(透明感のある黄褐色の液体)、下層(木タールと呼ばれる黒い油性の液体)、下層(木タールと呼ばれる黒い油性の液体)の3層に分かれます。中間層の透明感のある黄赤褐色の液体が粗木酢液で、さらに精製したものが木酢液です。
高品質の“高純度精製木酢液”を使用
大幸薬品の木酢入浴液は、蒸留精製を繰り返し行い、不純物である木タール分を除去した高品質の”高純度精製木酢液”を使用しています。高純度精製木酢液はどんなもの?
細菌や真菌を除菌“高純度精製木酢液”を添加したSCD培地(木酢入浴液濃度3%)と添加していないSCD培地に、皮膚常在菌の一種の最近Oを培養したとき、“高純度精製木酢液”を添加した場合には、最近Oは増殖がみられませんでした。
大幸薬品社内データ
![]() |
![]() |
| 添加なし | 高純度精製木酢液3%添加 |
“高純度精製木酢液”の抗真菌活性をdisc assayにより測定したところ、真菌(糸状菌2種類)に対して抑制がみられました。
※阻止円の直径の値が大きい程、真菌活性が高いことを示します。
大幸薬品社内データ
| 阻止円の直径(mm) | ||
| 糸状菌A | 糸状菌B | |
| 高純度精製木酢液 | 12.7±2.5 | 21.6±3.7 |
| 7%酢酸 | 6.5±1.2 | 11.6±2.2 |
すぐれた消臭
アンモニア(200〜250ppm)を一定量で木酢液で洗い流した後のアンモニアの濃度を測定しました。木酢液は2時間以上アンモニアの消臭効果を示しました。
大幸薬品社内データ
| 有害なホルムアルデヒドや発がん性のベンゾ[a]ピレンを徹底除去しています。 | 木酢入浴液の規格 規格(100mlに含まれる重量)
|
お湯をなめらかに、やさしく、温まります
木酢入浴液使用時のpH測定
健康な日本人の皮膚のpHは弱酸性(約4.5〜6.5)といわれ、木酢入浴液を入れると皮膚の最適なpHに近づいていくことがわかります。
木酢入浴液は水道水に10,000倍希釈した溶液(常用量と同様)を使用
大幸薬品社内データ
木酢入浴液使用による体表面温度の変化測定
木酢入浴液使用20分後の体表面温度の変化をサーモグラフィにて測定したところ、木酢入浴液を使用しない時には大部分が33℃以下でしたが、木酢入浴液を使用した時には、大部分が33℃以上でした。
木酢入浴液を使用したときのサーモグラフィ写真
常用量(木酢入浴液20mlを浴槽200Lに添加)で、40℃、10分間全身浴し20分後に測定
大幸薬品社内データ
| 商品名 | 木酢入浴液500ml |
| サイズ | 家庭用 通常サイズ 約25回分 |
| 希望小売価格 | 1,000円(税抜) |
| 内容量 | 500ml |
| 発売元 | 大幸薬品株式会社 |
| 商品名 | 木酢入浴液1000ml |
| サイズ | お徳用 大容量サイズ 約50回分 |
| 希望小売価格 | 1,700円(税抜) |
| 内容量 | 1,000ml |
| 発売元 | 大幸薬品株式会社 |